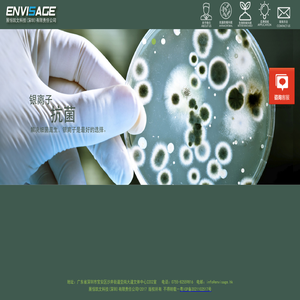
抗菌防霉,生物降解

Seo综合信息
SEO信息: 百度来访IP:- | 移动端来访IP:- | 出站链接:0 | 站内链接:11 IP网速: IP地址:120.24.83.38 [中国广东深圳 阿里云] | 网速:367毫秒 ALEXA排名: 世界排名:- | 预估IP:- | 预估PV:- 备案信息: 粤ICP备2021102517号 | 名称:展恒凯文科技(深圳)有限责任公司 | 已创建:7年9个月10天
收录 百度 360 搜狗 谷歌 查询 0 0 0 0
电脑关键词 手机关键词 页面友好 首页位置 索引 近期收录 0 0 电脑端优秀 - 0 0
协议类型HTTP/1.1 200 OK 页面类型text/html 服务器类型nginx 是否压缩是 原网页大小71484 压缩后大小9030 压缩比87.37%
网站快照抗 菌 防 霉 , 生 物 降 解 展 恒 凯 文 科 技 地 址 : 广 东 省 深 圳 市 宝 安 区 沙 井 街 道 坣 岗 大 道 文 体 中 心 2 2 0 2 室 电 话 : 0 7 5 5 8 2 5 5 9 8 1 6 电 邮 : i n f o @ e n v i s a g e . h k 展 恒 凯 文 科 技 ( 深 圳 ) 有 限 责 任 公 司 © 2 0 1 7 版 权 所 有 不 得 转 载 - 粤 I C P 备 2 0 2 1 1 0 2 5 1 7 号 / /
网站说明:www.envisagetech.cn由网友主动性提交被名站导航整理收录的,名站导航仅提供网站的基础信息并免费向大众网友展示,www.envisagetech.cn的IP地址:120.24.83.38 [中国广东深圳 阿里云],百度PC权重为0、百度手机权重为0、百度收录为0条、360收录为0条、搜狗收录为0条、谷歌收录为0条、百度来访流量大约在-之间、百度手机端来访流量大约在-之间、www.envisagetech.cn的备案号是粤ICP备2021102517号、备案主体是展恒凯文科技(深圳)有限责任公司、被百度收录的关键词有0个、手机端关键词有0个、该站点迄今为止已经创建7年9个月10天。
内容声明:1、本站收录的内容来源于大数据收集,版权归原网站所有!
2、本站收录的内容若侵害到您的利益,请联系我们进行删除处理!
3、本站不接受违规信息,如您发现违规内容,请联系我们进行清除处理!
4、本文地址:https://www.hornyrob.com/wangluodh/e8a909a6cfc0e21f7d7c.html,复制请保留版权链接!
 0
0 0
0 0
0 0
0